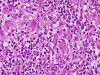
Com308-1-Ganglion-HM1.gif (115867 bytes)

Cerebellum
Cerebellum
Hippocampus
Parietal
Substantia nigra
Medulla




Medulla
Paravertebral sympathetic ganglion
Paravertebral sympathetic ganglion
| A 54 year-old Man with
Acute Onset Pain, Delusion, and Rapid Deterioration. August, 2003, Case 308-1. Home Page |
Xiaohe Yang 1, M.D., Jiang Qian, M.D., Ph.D.1, Kar-Ming Fung, M.D., Ph.D. 2 Last update July 30, 2003.
1 Department of Pathology, Albany Medical College, Albany, NY and 2 Department of Pathology, University of Oklahoma, Oklahoma City, OK.
Clinical information: The decedent was a 54-year-old male who presented in late September, 2000 with pain in his lower right back. Over the next 48 hours following his presentation, his back pain intensified and alternated with abdominal discomfort. The pain was described as sharp and needle-like. He also became restless and apprehensive. Initial evaluation disclosed pain in the flank and lower back with radiation to the groin. The patient was admitted under the clinical impression of bowel obstruction.
On physical examination, his temperature was 37.4°C. There was soft tissue swelling in the right lumbar area. There was also nausea, vomiting, abdominal cramps, and anxiety. Within three hours after admission, his conditions deteriorated and he developed dysphasia, dizziness, shortness of breath and paranoia. On the following morning, the patient became increasingly delusional and combative. There was also frothing and hyperexcitability. He was coded on the following morning and was resuscitated successfully. After a gradual decrease in heart rate, blood pressure, and respirations despite mechanical ventilatory support, he died 13 days after presentation.
Withheld Clinical Information: The patient came from Africa and had a history of dog bite. The location of the bite was not sure but was not related to the flank swelling.
Pathology of the case:
Gross pathology:
The brain weighed 1300 gm and was slightly edematous. The leptomeninges was translucent and free of exudates. Minimal atherosclerotic changes were present in the major arteries. On coronal sections, there were multiple geographic necrotic areas along the core of the cerebrum that ran bilaterally from the head of the caudate to the occipital lobe. Bilateral basal ganglia, thalamus and hypothalamus were diffusely necrotic. The gray-white demarcation in this region is blurred. There was no intraventricular or parenchymal hemorrhage. The choroids plexus was free of macroscopic pathologic changes. The cerebellum and brain stem were free of macroscopic pathologic changes.
Histopathology:
 |
 |
 |
 |
 |
 |
|
A. Cerebellum |
B. Cerebellum |
C. Hippocampus |
D. Parietal |
E. Substantia nigra |
F. Medulla |
 |
 |
|
 |
||
|
G. Medulla |
H. Paravertebral sympathetic ganglion |
I. Paravertebral sympathetic ganglion |
J. |
The overall tissue preservation is less than optimal because of postmortem autolysis. Panel A and B are taken from the cerebellum. The molecular layer, Purkinje cell layer, and internal granular layer are included (Panel A). Solitary eosinophilic intracytoplasmic inclusions of variable size are present in the Purkinje cells. No inflammatory cell infiltration is present in the cerebellum. The vacuolar spaces (Panel B) is partly due to autolysis and partly due to hypoxic/ischemic changes. Pyramidal cells in the hippocampus (Panel C), cortical neurons in parietal lobe (Panel D) and other neocortical areas adopted an elongated and contracted contour with loss of nuclear details. These are histologic features consistent with hypoxic/ischemic changes. Similar to the cerebellum, solitary eosinophilic cytoplasmic inclusion bodies are present and there is no inflammatory cell infiltration. Multiple eosinophilic cytoplasmic inclusion bodies within a single neuron are occasionally found. Some of these neurons containing multiple inclusions from the substantia nigra are illustrated in Panel E. Although inflammatory cell infiltration is scant in the cerebrum and cerebellum, perivascular chronic inflammatory cell infiltrations are common in the medulla (Panel F and G), in the paravertebral sympathetic ganglion (Panel H and I) and in the spinal cord (not shown). Intracytoplasmic inclusions, however, are not found in the medulla, spinal cord, and paravertebral sympathetic ganglion. Under the electron microscope, rod-shape or bullet-shaped viral particles are found (Panel J).
Comment: The amount of inflammation in the medulla, paravertebral sympathetic ganglion and the spinal cord is on the intense side of this entity.
|
DIAGNOSIS: Rabies |
Discussion: General information Pathogenesis Clinical features Pathologic features Diagnosis
Rabies
is a disease of both human and animals. Several excellent reviews on this topic
are avialable 1,
2,
3,
4.
Rabies has a global distribution but some island countries and territories such
as Hawaii, Britain, Japan and Australia have been rabies free for many years.
Vivid descriptions on the manifestations of rabies in human and animals can be
found in ancient and modern literatures. Sadly, this ancient disease is, to this
date, a virtually fatal one with horrific clinical manifestations. The
number of human death from rabies in Asia is 100 times higher than that of the
Americas and Africa combined
5.
Most cases occurs in the Indian subcontinent. Rabies is a rare disease
in the United States and only 36 cases have been reported from 1980 to 1999
6.
Rabies virus is capable of infecting most warm-blooded animals. Most cases are transmitted by the inoculation of saliva of a rabid animal, usually through bites, into a wound. In some pediatric cases, the wound was not reported by the child and was unnoticed by the parents until clinical manifestations occur. While dog bites account for most cases of human rabies in the world, the successful efforts in control of rabies in domestic animals in North American and Western Europe have shifted the source of infection to wild animals or sylvan animals in these regions. Foxes, raccoons, skunks, coyotes, wolves, mongooses, and bats are all major wild-animal reservoirs of rabies. Insectivorous bats have recently been a significant source of human disease in the United States 3. Although uncommon in other geographic regions, 21 of the 36 cases of rabies diagnosed in the United States from 1980 to 1999 were caused by insectivorous bats. Many of these were inflicted by bites but two cases were caused by aerosol transmission in humid bat-caves 5. Recent implementation of vaccination program in wild animals may help to decrease incidence of human infection. Additional information can be obtained at the RABNET (http://globalatlas.who.int/interactivemap/rabies/) of the World Health Organization.
Rabies
is an enveloped single strand RNA virus of the genus Lyssavirus in the
family Rhabdovirus. This family of viruses infect a wide variety of mammals,
fish, birds, and plants. The virus is rod shaped (Greek Rhabdos, meaning
“rod”) and its envelope contains a G protein, an externally protruding spike
of transmembrane virual glycoprotein that allows the virus to bind to
cell-surface receptors to initiate fusion of the envelope with the cytoplasmic
membrane and subsequent endocytosis of the virus. Receptors include the
nicotinic acetylcholine receptor and neural cell adhesion molecule (NCAM; CD56)
7,
8.
There is sequence homology between the G protein of rabies virus and the region
with the greatest binding affinity for the acetylcholine receptor
9.
The genome is a negative-sense 12-kb RNA. A positive intermediate genome is
synthesized and acts as a template for the synthesis of new genomes. Replication
occurs in a circumscribed region that corresponds to the Negri body (vide
infra). The viral envelope is acquired by budding through the modified
cytoplasmic membrane or endoplasmic reticulum of the host cell. Rabies virus is
inactivated by detergents rapidly, a feature that makes local wound care and
cleaning with high concentration of soap and water a critical, probably most
important and efficient step in the prevention of rabies. The virus is also
rapidly inactivated by exposure to ultraviolet light, sunlight, desiccation,
formalin, phenol,
b-propiolactone,
and ether 3.
Rabies transmitted through inoculation in muscle, most commonly through animal
bites in non-experimental setting, would go through an initial phase of local
replication at the inoculation site. The virus is then taken up by axons at the
neuromuscular junction and transported to the central nervous system (CNS). This
initial phase in humans occur within days but may be delayed for several months.
Once the virus has reached the CNS, there is rapid proliferation and spread
throughout the CNS
4.
The virus could then be centrifugally transported to peripheral tissues
including the salivary glands, lacrimal glands, cornea, nuchal skin, and many
other organs. As a result, the tears and saliva act as infectious vehicles to
infect other animals through, predominantly, bites.
Since
rabies can be spread by contact with saliva, tears, and other body fluid of an
infected animal, any exposure to an infected and rabid animal should be
considered as a possibility for infection and appropriate postexposure measures
should be taken. Appropriate measures include prompt local wound care,
administration of rabies immunoglobulin (RIG) and human diploid cell vaccine (HDCV).
Detailed discussion on the management is beyond the scope of this article.
Interested readers are referred to the publications by Baer 2
and Whitley 3.
The incubation phase for rabies is extremely variable. It can range from days to years. For about half of the cases, the range is between 60 to 90 days. The incubation period is shorter in children than adults. It also varies with the proximity of the location of inoculation to the CNS. Bite wounds in the craniofacial areas have the shortest incubation time and are probably caused by direct inoculation of the virus into peripheral nerves that are close to the brain.
A prodromal period with
“flu-like” symptoms may occur and lasts for up to 2 weeks. About
four-fifth of the cases would manifest as “furious” (encephalitic) type of rabies
and the remaining one-fifth as the “dumb” (paralytic) type. The two forms
may overlap. Clinical manifestations of the encephalitic type include agitation,
behavioral changes, hyperactivity, hallucinations, and extreme excitability.
Many of the patients will develop hydrophobia consisting of episodes that last 1
to 5 minutes and are associated with aversion to drinking water. Focal or
generalized seizures may occur and are associated with high mortality 3.
Clinical manifestations of the paralytic type include paralyze of one to
all four limbs. There is combined motor and sensory involvement similar to that
of Guillain-Barré syndrome. Death usually occurs in 1-2 weeks after the onset of acute
neurological disease.
The brain and spinal cord may appear swollen but are usually free of focal lesions. Histopathologically, rabies is a widespread polioencephalomyelitis. Leptomeningeal and parenchymal perivascular lymphocytic infiltrations are usually present but often not intense. Neuronophagia can also be seen. The amount of inflammation of the case under discussion is, in fact, on the intense side of the scale. The pathognomonic Negri bodies 10, 11, 12 are sharply delineated, round to oval, eosinophilic, neuronal cytoplasmic inclusions; first described by Negri in 1903 10. These inclusions are often solitary but may also be multiple in a single neuron. Lyssa bodies refer to less well delineated and more pleomorphic neuronal cytoplasmic viral inclusions. Babes’ nodules refer to clusters of microglia that remain after destruction of neurons. When immunohistochemistry is employed, the distributions of viral antigen are far more extensive than that estimated by conventional light microscopy 13. Negri body and rabies viral antigen as demonstrated by immunohistochemistry are most commonly seen in large neurons of the hippocampus (Pyramidal cells), cerebellum (Purkinje cells), thalamus, basal ganglia, cerebral cortex and in the brain stem, especially gray matter of the pons and medulla. They are also found in spinal cord motor neurons and dorsal root ganglion, especially in the paralytic form. Immunohistochemistry also demonstrated rabies viral antigen in astrocytes and oligodendrocytes 13. Characteristically, a striking discrepancy between the degree of inflammation and amount of inclusion bodies is observed, as in our case, in many cases.
When the appropriate clinical and epidemiological information is lacking, rabies can be a diagnostic challenge 14. A high index of suspicion would be helpful. The diagnosis of rabies after centrifugal spread of virus to peripheral tissues has occurred can be achieved by immunofluorescent staining of corneal impression or biopsy of nuchal skin 15. These sites appeared to be the more appropriate locations for antemortem diagnostic biopsy for their proximity to the brain, the source of viruses for centrifugal spread. Skin biopsy has a sensitivity of 50-90% and the specificity is nearly 100%. Corneal impression is more likely to have false negative results 16, 17 and is replaced by nuchal skin biopsy. Viral isolation and serologic studies of the cerebral spinal fluid and serum are an alternative approach of antemortem diagnosis. Neuropathologic examination of the CNS and also peripheral organs with the help of immunohistochemical studies would establish a firm postmortem diagnosis.Reference:
Baer
GM. The Natural History of Rabies. Academic Press, New York. 1975.
Baer
GM, Bellini WJ, Fishbein DB, Rhabdoviruses. In: Fields BN, Knipe DM,
Chanock RM et al., eds. Virology, pp. 883-930. Raven Press, New York.
1990.
Whitley
RJ. Rabies. In: Scheld WM, Whitley RJ, and Durack DT. Infections
of the Central Nervous System, pp 181-198. Lippincot-Raven, New York.
Hemachudha
T, Phuapradit P.
Rabies.
Curr
Opin Neurol.
1997 10:260-7.
World
Health Organization. World
Survey of Rabies
No.
33 for the Year 1997.
Centers
for Disease Control.
Human rabies
prevention--United States, 1999. Recommendations of the Advisory Committee
on Immunization Practices (ACIP). MMWR
1999
48(RR-1):1-21. Errata
published in MMWR 1999 48:16.
MMWR 2000 49:737.
Baer
GM, Shaddock JH, Quirion R, Dam TV, Lentz TL.
Rabies
susceptibility and acetylcholine receptor. Lancet.
1990 335:664-5.
Thoulouze
MI, Lafage M, Schachner M, Hartmann U, Cremer H, Lafon M.
The
neural cell adhesion molecule is a receptor for rabies virus. J
Virol.
72:7181-90.
Lentz
TL, Wilson PT, Hawrot E, Speicher DW.
Amino acid sequence similarity between rabies virus glycoprotein and
snake venom curaremimetic neurotoxins. Science.
1984 226:847-8.
Negri
A. Zur aetiologie der tollwuth. Die diagnose der tollwuth auf grund der
neuen befunde. Z. Hyg Infectionskr 1903 44:519-540.
Kristensson
K, Dastur DK, Manghani DK, Tsiang H, Bentivoglio M.
Rabies:
interactions between neurons and viruses. A review of the history of Negri
inclusion bodies. Neuropathol
Appl Neurobiol.
1996 22:179-87.
Mrak
RE, Young L.
Rabies
encephalitis in humans: pathology, pathogenesis and pathophysiology. J
Neuropathol Exp Neurol.
1994 53:1-10.
Tirawatnpong
S, Hemachudha T, Manutsathit S, Shuangshoti S, Phanthumchinda K, Phanuphak
P.
Regional
distribution of rabies viral antigen in central nervous system of human
encephalitic and paralytic rabies. J
Neurol Sci.
1989 92:91-9.
Hemachudha
T, Laothamatas J, Rupprecht CE.
Human
rabies: a disease of complex neuropathogenetic mechanisms and diagnostic
challenges. Lancet
Neurol.
2002 1:101-9.
Blenden
DC, Creech W, Torres-Anjel MJ.
Use
of immunofluorescence examination to detect rabies virus antigen in the skin
of humans with clinical encephalitis. J
Infect Dis.
1986 154:698-701.
Larghi
OP, Gonzalez E, Held JR.
Evaluation
of the corneal test as a laboratory method for rabies diagnosis. Appl
Microbiol.
1973 25:187-9.
Schneider
LG.
The
cornea test; a new method for the intra-vitam diagnosis of rabies. Zentralbl
Veterinarmed B.
1969 16:24-31.